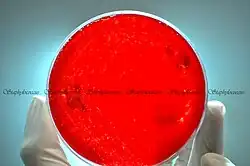

Staphylococcus aureus
| Staphylococcus aureus | ||
|---|---|---|
![]() Bacteria S. aureus escapando de la destrucción por leucocitos humanos. | ||
![]() S. aureus, micrografía electrónica de barrido, color artificial. | ||
| Taxonomía | ||
| Dominio: | Bacteria | |
| Reino: | Bacillati | |
| Filo: | Bacillota | |
| Clase: | Bacilli | |
| Orden: | Bacillales | |
| Familia: | Staphylococcaceae | |
| Género: | Staphylococcus | |
| Especie: |
S. aureus Rosenbach 1884 | |
Staphylococcus aureus (pronunciación: /ˌstafiloˈkokus ˈawrews/), conocido como estafilococo áureo o estafilococo dorado, es una bacteria anaerobia facultativa, grampositiva, productora de coagulasa, catalasa, inmóvil y no esporulada que se encuentra ampliamente distribuida por todo el mundo, estimándose que una de cada tres personas se hallan colonizadas, aunque no infectadas, por ella.[1]
Puede producir una amplia gama de enfermedades, que van desde infecciones cutáneas y de las mucosas relativamente benignas, tales como foliculitis, forunculosis o conjuntivitis, hasta enfermedades de riesgo vital, como celulitis, abscesos profundos, osteomielitis, meningitis, sepsis, endocarditis o neumonía. Además, también puede afectar al aparato gastrointestinal, ya sea por presencia física de Staphylococcus aureus o por la ingesta de la enterotoxina estafilocócica secretada por la bacteria.
En la actualidad, este microorganismo se encuentra como el principal causante de las infecciones nosocomiales. Esta situación se ve favorecida por el hecho de que esta especie habita tanto en las mucosas como en la piel de los seres humanos, lo que permite que a través de las heridas quirúrgicas pueda penetrar en el torrente sanguíneo del paciente por medio del contacto directo o indirecto con el personal sanitario, con un objeto contaminado o incluso con otro paciente.[2]
Las cepas habituales de Staphylococcus aureus son resistentes a la penicilina, dejando como los antibióticos más eficaces para combatirlos a los aminoglucósidos, la oxacilina o la nafcilina.[3] Además de la administración del tratamiento antimicrobiano correspondiente, puede ser conveniente, en función del caso, la eliminación de puertas de entradas como catéteres venosos permanentes o drenajes quirúrgicos.
Historia
Este microorganismo fue descrito por primera vez en el año 1880, concretamente en la ciudad escocesa de Aberdeen, por el cirujano Alexander Ogston en el pus que drenaba un absceso infectado.[3] En 1884 Friederich Julius Rosenbach acuñó el nombre binominal de esta especie. En 1903, Loeb realiza el descubrimiento de la coagulasa y Elek, en 1959, hace un estudio sobre Streptococcus pyogenes, abarcando una revisión sobre todas las interrogantes existentes para la época.[2] En 1941 las infecciones estafilocócicas eran erradicadas por penicilina. Un poco más tarde, en 1945, Sprink Ferris reportó una cepa de S. aureus resistente a la penicilina que, por la acción de una β-lactamasa, la destruía.[2][4] Para 1950, con la introducción de la penicilina y las sulfonamidas, los estreptococos fueron desplazados por los estafilococos como agentes de infección intrahospitalaria; y para 1959, año en que apareció la meticilina (una penicilina semisintética), 60% de las cepas ya eran resistentes a penicilina.[4] En 1961 Jevons hizo el primer reporte de la existencia de un Staphyloccocus aureus resistente a meticilina; cuando esta era una causa importante de infección nosocomial en Europa.[5]
Concepto
El nombre binominal de esta bacteria proviene de la raíz griega σταφυλόκοκκος, que se compone de staphylé, que significa racimo y coccus, que significa grano, baya o uva; y del latín aureus que significa dorado. Este nombre significa "racimo de uvas doradas" y lo lleva en función de su morfología microscópica y el color dorado de las colonias en los cultivos.
Epidemiología
_Bacteria.jpg)
Staphylococcus aureus es un agente patogénico ubicuo que es considerado como parte de la microbiota normal, se encuentra en la piel del individuo sano pero en ocasiones en que las defensas de la piel caen puede causar enfermedad.[4] El principal grupo de riesgo son pacientes hospitalizados o inmunocomprometidos. Cerca de 2000 millones de personas han sido colonizadas mundialmente por este microorganismo.[6]
Los seres humanos son un reservorio natural de S. aureus. Entre el 30 y el 50% de los adultos sanos están colonizados, y entre el 10 y el 20% se mantienen colonizados persistentemente.[2] Esta bacteria forma parte de la microbiota normal del ser humano y tiene colonización selectiva de narinas (20-40%, en adultos), pliegues intertriginosos, perineo, axilas y vagina, no obstante, las personas colonizadas tienen un riesgo mayor de sufrir infecciones.[1]
La colonización por S. aureus se da preferentemente en:[2]
- Personas con diabetes tipo 1;[7]
- Usuarios de drogas intravenosas;[8]
- Pacientes con hemodiálisis;[9]
- Pacientes quirúrgicos;[10]
- Personas con sida.[11]
Los estafilococos se diseminan por las actividades domésticas y comunitarias tales como hacer la cama, vestirse o desvestirse. El equipo de salud es uno de los principales vectores biológicos de diseminación de esta bacteria.[3][12] Se ha visto que los manipuladores de alimentos contribuyen a diseminar Staphylococcus aureus enterotoxigénicos, contribuyendo al desarrollo de intoxicaciones alimentarias.[13]
Se ha visto un incremento en la incidencia de infecciones nosocomiales por Staphylococcus aureus desde 1970.[3] Durante el periodo de 1990 a 1992, S. aureus fue una de los agentes etiológicos de neumonía adquirida en hospitales.[14] Así mismo, se ha notado un incremento considerable, probablemente debido a la presión antibiótica, de cepas con resistencia a diferentes fármacos antimicrobianos. Entre ellos están el estafilococo resistente a meticilina y el estafilococo resistente a vancomicina.[3]
Entre los factores de riesgo que predisponen a infecciones graves por S. aureus se encuentran:[1]
- Defectos en la quimiotaxis de leucocitos (como: Síndrome de Wiskott-Aldrich, Síndrome de Chediak-Higashi, Síndrome de Down,...);
- Defectos en la opsonización por anticuerpos (como agammaglobulinemia primaria);
- Defectos en la fagocitosis (como enfermedad granulomatosa crónica);
- Lesiones cutáneas (como quemaduras);
- Presencia de cuerpos extraños (como suturas o prótesis);
- Infección por otros agentes;
- Algunas enfermedades crónicas (como diabetes mellitus);
- Consumo de antibióticos.
Morfología

S. aureus es un coco inmóvil, de 0,5 a 1 μm de diámetro,[15] que se divide en tres planos para formar grupos de células irregulares semejantes a racimos de uvas. En extendidos de pus los cocos aparecen solos, en pares, en racimos o en cadenas cortas. Los racimos irregulares son característicos de extendidos tomados de cultivos que se desarrollan en medios sólidos, mientras que en otros cultivos son frecuentes las formas de diplococos y en cadenas cortas. Unas pocas cepas producen una cápsula o capa de baba que incrementa la virulencia del microorganismo. S. aureus es un microorganismo grampositivo pero las células viejas y los microorganismos fagocitados se tiñen como gramnegativos.
Envoltura celular bacteriana
Cápsula y capa de polisacárido extracelular
_Bacteria.jpg)
Se han reportado cepas de S. aureus que se encuentran recubiertas por una capa de polisacáridos externos, la cual recibe el nombre de slime o cápsula mucoide, que incrementa su capacidad de adherencia, evita que sea reconocido, así como refuerza el efecto antifagocítico. Hasta ahora se han identificado once serotipos capsulares de S. aureus. Los serotipos con las cápsulas más gruesas son el 1 y el 2, y forman colonias mucoides, no obstante, no se asocian con enfermedad. Los serotipos 5 y 8 son los responsables de la mayor parte de las infecciones humanas[15] y específicamente el serotipo 5 engloba a la mayoría de las cepas de S. aureus Resistente a Meticilina (véase más adelante).[2]
La capa polisacárida extracelular es producida por algunas cepas de S.aureus y les confiere la capacidad de adherirse a las células huésped diferentes objetos protésicos, como catéteres, injertos y prótesis plásticas. Esta adherencia poco común se debe a la capa de polisacárido extracelular, formada por monosacáridos, péptidos y proteínas, que es producida por la mayor parte de los estafilococos. La producción de estos dos materiales está influida por factores como la composición del medio y las condiciones de desarrollo.[15][1]
Peptidoglucano

El peptidoglucano forma aproximadamente el 50% del peso de la pared celular en seco.[3] Está compuesto por cadenas de 10 a 12 glucanos, entre los que destacan el ácido N-acetilmurámico y N-Acetilglucosamina unidos mediante enlaces β 1,4. Estos glucanos se encuentran entrecruzados por oligopéptidos y un puente de pentaglicina por la β-N-acetilglucosaminidasa (específico para S. aureus). En el caso de S. aureus las cadenas de glucano se entrecruzan mediante puentes de pentaglicina unidos a L-Lisina y D-Alanina. El peptidoglucano funciona como estabilizador osmótico y evita la lisis de la bacteria por las diferencias en la concentración de sal. El peptidoglucano tiene una actividad tipo endotoxina y estimula la quimiotaxis de neutrófilos, lo que contribuye a la formación de abscesos. Las proteínas ligadoras de penicilina (PBP) son enzimas que catalizan la construcción de peptidoglucano.[15]
Las diferencias en la estructura del peptidoglucano en cepas de S. aureus constituyen diferencias en su capacidad de causar coagulación intravascular diseminada.[16]
Ácidos teicoicos
El ácido teicoico supone aproximadamente el 30% del peso de la pared celular en seco. Los ácidos teicoicos son polímeros de fosfato de ribitol[3] unidos mediante enlaces fosfodiéster (diferentes para cada especie bacteriana). Se unen a residuos del ácido N-acetilmurámico de la capa de peptidoglucano o se anclan lipofílicamente a la membrana citoplasmática (ácidos lipoteicoicos). Son inmunógenos cuando se encuentran unidos al peptidoglucano y estimulan una respuesta de tipo humoral, activan el complemento, mejoran la quimiotaxis de los leucocitos polimorfonucleares y activan la producción de interleucina 1. Los ácidos teicóicos actúan en la adherencia específica de las bacterias grampositivas a las superficies mucosas y presenta afinidad por fibronectina.[1][15]
Catalasa
La catalasa funciona para catalizar la destrucción de peróxido de hidrógeno en oxígeno y agua, y es de utilidad para evitar la formación de radicales tóxicos formados por el sistema de la mieloperoxidasa en las células fagocíticas.[17] La catalasa constituye un blanco para pruebas de identificación bioquímica (véase más adelante).
Proteína A
Las cepas de S. aureus se caracterizan por estar recubiertas de proteína A (42 kDa/508 aa).[18] Esta proteína se acopla a la capa de peptidoglucano o a la membrana citoplasmática. Tiene afinidad por la fracción Fc de las inmunoglobulinas IgG (subtipos IgG1, IgG2, IgG4) lo que le permite fijarlas por el extremo cristalizable (como sostener una espada por el mango y evitar el extremo filoso), de esta manera evita ser opsonizado y fagocitado. Esta proteína es inmunógena y se encuentra (junto con anticuerpos contra ella) en el suero de individuos con infecciones severas por S. aureus.[1] Se han desarrollado pruebas en busca de esta proteína en muestras de S.aureus, no obstante no superan en efectividad a otras pruebas más sencillas.[15]
Coagulasa
Coagulasa es un activador de protrombina[3] presente en la mayoría de las cepas de S. aureus, también conocida como factor de agregación y constituye una prueba muy sensible y específica para esta bacteria. Esta proteína representa un importante factor de virulencia. La coagulasa puede unirse al fibrinógeno y convertirlo en fibrina insoluble, la cual tiende a formar depósitos donde los estafilococos pueden agregarse (semejando a las plaquetas) y formar grupos.[15]
Otras estructuras
La membrana citoplasmática de S. aureus no presenta nada en especial. Las proteínas de superficie del estafilococo poseen características en común, tales como:[2]
- Una secuencia de señal secretoria en el extremo amino terminal, con aminoácidos catiónicos, extendida hasta el citoplasma;
- Un extremo hidrofóbico que se extiende hasta la membrana;
- Una región de anclaje a la pared celular en el extremo carboxilo terminal;
- Un dominio de adherencia en el extremo amino terminal.
Metabolismo
Staphylococcus aureus se desarrolla rápidamente en todos los medios, fermentan lentamente en carbohidratos, como el manitol, pero no produce gas. La actividad proteolítica varía mucho de una cepa a otra. S. aureus produce pigmentos que varían desde un color blanco hasta un amarillo intenso.[17]
Staphylococcus aureus tiene un metabolismo anaerobio facultativo, con excepción de las subespecies Staphylococcus aureus anaerobius y Staphylococcus aureus saccharolyticus que crecen de forma anaerobia y a menudo son catalasa-negativas.[1]
Genoma
S. aureus tiene un cromosoma circular de aproximadamente 2800 kilopares de bases, sin contar el material genético de prófagos, plásmidos y transposones.[3] Los factores de virulencia de la bacteria están contenidos en todos estos vehículos. Estos genes pueden ser transferidos entre las diferentes cepas de estafilococos, entre especies diferentes y también entre bacterias gram-positivas mediante vectores.[2]
La virulencia del estafilococo se regula genéticamente. Se han identificado varios genes reguladores, el más estudiado es el gen agr (accesory gene regulator). El knock-out de este gen causa una marcada disminución en la virulencia.[19]
-
Prueba para detectar la catalasa, al aplicar peróxido de hidrógeno se nota la aparición de pequeñas burbujas de oxígeno. -
Proteína A unida a las fracciones Fab y Fc de una inmunoglobulina. -
Prueba para detectar a la coagulasa donde se observa la coagulación del suero (coagulasa-positivo).
-
Prueba de fermentación de manitol, donde el cambio de color indica el uso del manitol.
Patogenia
S. aureus tiene a su disposición un amplio arsenal contra las defensas del hospedero. Los mecanismos patógenos de este microorganismo dependen de sus factores adhesivos, las toxinas y enzimas estafilocócicas y sus defensas contra la inmunidad.
| Factor de virulencia | Función |
|---|---|
| Componentes estructurales | |
| Cápsula | Inhibe quimiotaxis y dificulta la fagocitosis. |
| Capa de polisacáridos extracelulares | Facilita la adherencia a los cuerpos extraños (como cables de marcapasos, catéteres, etc.). |
| Peptidoglucanos | Evita la lisis celular (estabilizador osmótico). Estimula la producción de pirógeno endógenos. Quimiotaxis leucocitaria --> Abscesos. |
| Ácido teicoico | Media la adherencia del estafilococo a fibronectina, un componente mayoritario del tejido conectivo. |
| MSCRAMM | Aumenta su adherencia tisular. |
| Proteína A | Protección contra la inmunidad humoral. Fija anticuerpos por la porción Fc. Propiedades anticomplemento. |
| Enzimas | |
| Coagulasa | Cataliza la conversión de fibrinógeno en fibrina provocando el depósito de S. aureus, al estar cubierto por fibrina se vuelve menos inmunógeno. |
| Hialuronidasa | Cataliza la destrucción del ácido hialurónico en el tejido conjuntivo para ayudar a la diseminación del estafilococo. |
| Fibrinolisina | Disuelve coágulos de fibrina. |
| Lipasas | Promueven la hidrólisis de lípidos lo que hace que S. aureus se disemine en el tejido cutáneo y subcutáneo. |
| Endonucleasas/DNasas | Hidrólisis de DNA. |
| β-lactamasa | S. aureus posee 3 tipos. Por lo general residen en plásmidos. |
| Toxinas | |
| Citotoxinas | Destruye células (véase texto). |
| Toxinas exfoliativas (ETA, ETB) |
Serina proteasas que atacan a la Desmogleína-1. Síndrome de piel escaldada por estafilococo. |
| Enterotoxinas | Produce diarrea por apertura de canales o muerte de enterocitos. Algunas son superantígenos. |
| TSST-1 | Superantígeno que activa una gran cantidad de linfocitos con una producción masiva de citocinas. Síndrome del shock tóxico. |
Factores de adhesión
Existen diferentes proteínas de adhesión llamadas MSCRAMM (Componentes de la superficie microbiana que reconocen moléculas adhesivas de la matriz), propias de los estafilococos. El ácido teicoico tiene una gran afinidad como fibronectina. Estos factores adhesivos permiten que S. aureus pueda unirse a fibronectina, fibrinógeno, elastina y colágeno.
Toxinas
S. aureus produce muchas y muy variadas toxinas. Estas toxinas se dividen en 4 tipos: citotoxinas, enterotoxinas, toxinas exfoliativas y toxinas del choque tóxico.[20]
Citotoxinas
Una citotoxina es una toxina citolítica que causa daño directo a la membrana celular de las células del hospedero, se han identificado y aislado 5 toxinas: toxina-α, toxina-β, toxina-γ, toxina-δ y la leucocidina de Panton-Valentine (P-V).
Hemolisina-α
La toxina alfa (hemolisina alfa) es un polipeptido de 33 kDa que se introduce en las regiones hidrofóbicas de la membrana citoplasmática de células como eritrocitos, hepatocitos, leucocitos, miocitos (también músculo liso vascular) y plaquetas; donde forma poros de 1 a 2 nm de diámetro. Estos poros causan un desequilibrio osmótico importante debido a la salida rápida de K+ y la entrada de Na+ y Ca++ que termina en lisis celular. Se secreta en la fase de crecimiento logarítmico y es codificada por el cromosoma bacteriano aunque puede ser codificada por plásmidos adquiridos. Es especialmente neurotóxica ya que causa la degeneración de la vaina de mielina.
Hemolisina-β
La toxina beta (hemolisina beta) es una esfingomielinasa, también conocida como esfingomielinasa C, es una proteína presente en la mayoría de las cepas de S. aureus. Esta enzima tiene una masa de 35 kDa y es termolabil (sensible al calor). Tiene afinidad por la esfingomielina y lisofosfatidil colina (componentes de la membrana citoplasmática del hospedero) y cataliza su destrucción, con lo que trae toxicidad para distintas células como eritrocitos, fibroblastos, leucocitos y macrófagos.[1][15]
Hemolisina-δ
La toxina delta (hemolisina delta) es un pequeño polipéptido de 3 kDa producido por la gran mayoría de las cepas de S. aureus (y también por Staphylococcus epidermidis y Staphylococcus haemolyticus). Se produce en la fase de crecimiento tardío. Se cree que esta toxina actúa como un surfactante que actúa como detergente en las membranas de las células blanco, afecta a todas las células en general, pero en especial a eritrocitos.
Toxina-γ y leucocidina P-V
| Subunidad S | Subunidad F | Características |
|---|---|---|
| HlgA | HlgB | Alta actividad hemolítica |
| HlgC | HlgB | Alta actividad hemolítica |
| HlgA | LukF-PV | Alta actividad hemolítica |
| LukS-PV | Lukf-PV | Leucocidina de Panton-Valentine Es leucotóxica, pero no hemolítica |
| Elaborado sobre la base de: Lina, Piémont, Godail-Gamotl et al[21] y Murray[15] | ||
La toxina gama (hemolisina g) y la leucocidina Panton-Valentine son estructuralmente similares. Ambas tienen actividad hemolítica y constan de dos subunidades. La subunidad S (de Slow-elution) es una proteína de elusión lenta, se han identficado 3 (HlgA [Hemolisina-g A], HlgC [Hemolisina-g C] y LukS-PV [Leucocidina Panton-Valentine S]). La subunidad F (de Fast-elution) es una proteína de elusión rápida, se han identificado 2 (HlgB [Hemolisina-g B] y LukF-PV [Leucocidina Panton-Valentine F]. Estas subunidades pueden cambiarse entre sí de manera que exista siempre 1 subunidad S y una F, así, si una bacteria posee todos los genes podría producir 6 toxinas diferentes. Actúan de forma similar a la toxina alfa, forma poros con aumento de la permeabilidad de cationes, desequilibrio osmótico y lisis celular.[15][21]
La leucocidina de Panton-Valentine (PVL) tiene más actividad leucotóxica que todas las demás, pero no es hemolítica. Se encuentra en <5% de las cepas de S. aureus resistente a la meticilina (SARM) intrahospitalarias y prácticamente en todas las cepas SARM comunitarias. La producción de esta ha sido preferentemente vinculada a los forúnculos, abscesos cutáneos, e infecciones graves de la piel necrótica.[21]
Los genes que codifican a PVL han sido localizados en el fago ATCC 49775 que contiene a luks-PV y lukF-PV y aproximadamente a más de 60 marcos de lectura, algunos de los cuales podrían tener una participación en la virulencia de S. aureus.[21]
Enterotoxinas


Las enterotoxinas estafilocócicas constituyen un grupo heterogéneo de proteínas solubles en agua, presentan un peso molecular bajo que oscila entre 26 kDa y 30 kDa. Estas toxinas provienen de cepas específicas aunque una cepa de Staphyloccocus aureus puede sintetizar múltiples serotipos toxigénicos. Las enterotoxinas están asociadas a intoxicaciones alimentarias, son producidas por el 30% de S.aureus. Las enterotoxinas estafilocócicas son termorresistentes, algunas pueden mantenerse estables incluso al calentar los alimentos más de 100 °C durante 30 minutos,[15] y son resistentes a la hidrólisis por enzimas gástricas y pancreáticas. Se cree que su mecanismo de acción consiste en actuar como superantígenos, con la subsecuente liberación de citocinas responsables de los síntomas alimentarios. Se conocen 7 serotipos enterotoxigénicos diferentes: A, B, C1, C2 C3, D y E.[22] La detección de enterotoxinas en las cepas de S. aureus es sencilla y se realiza mediante pruebas con antisueros, que tienen un costo relativamente elevado y no modifican el umbral terapéutico. Por esta razón generalmente no se realiza y se asume que las cepas productoras de coagulasa y termonucleasa son enterotoxigénicas, no obstante, la Food and Drug Administration (FDA) establece que la sola presencia de grandes cantidades de S. aureus en los alimentos no constituye evidencia suficiente para incriminar un alimento como causante de intoxicación.[13]
| Enterotoxina | Comentario |
|---|---|
| Enterotoxina A | Asociada a la mayoría de las intoxicaciones alimentarias. |
| Enterotoxina B | Produce colitis pseudomembranosa y se encuentra con regularidad en infecciones intrahospitalarias. |
| Enterotoxina C | Se atribuye a productos lácteos contaminados. |
| Enterotoxina D | También se asocia a un gran número de intoxicaciones y se atribuye a productos lácteos contaminados. |
Toxinas exfoliativas
Las toxinas exfoliativas son proteasas de serina que catalizan la destrucción de la proteína desmogleína-1, una proteína que mantiene adheridos a los queratinocitos del estrato granuloso en la epidermis. Están presentes en menos del 10% de los estafilococos. Estas toxinas están relacionadas con el síndrome de piel escaldada por estafilococo, una enfermedad secundaria a la dermatitis exfoliativa mediada por estas toxinas. Existen dos formas distintas de toxinas exfoliativas en S. aureus, ETA [Exfoliative toxin A] y ETB [Exfoliative toxin B].[15]
ETA es codificada por un gen cromosómico y es termoestable, mientras que ETB es codificada por un plásmido y es termolábil.
Toxina-1 del síndrome de shock tóxico

La Toxina-1 del síndrome de shock tóxico (TSST-1) es una toxina de 22 kDa termoestable y resistente a proteólisis que produce el síndrome de shock tóxico al actuar como un superantígeno. Esta patología está asociada con la infección de una herida por S. aureus.
Esta toxina es estructuralmente parecida a las enterotoxinas B y C, y el gen que la codifica está presente en el 20% de las cepas de S. aureus.[2]
Enzimas
Los estafilococos producen varias enzimas, proteasas, lipasas e hialuronidasas que destruyen tejidos. Estas facilitan la diseminación de la infección a los tejidos adyacentes.
Coagulasa
S. aureus produce dos formas de coagulasa, una que se encuentra ligada a la membrana (coagulasa ligada, ya revisada) y otra coagulasa libre. La coagulasa libre, a diferencia de la coagulasa ligada, no cataliza la reacción directa entre fibrinógeno y fibrina, su mecanismo de acción es modificar el factor de reacción con la coagulasa a estafilotrombina, un producto semejante a la trombina. Estafilotrombina es el factor que cataliza la conversión de fibrinógeno a fibrina, que formará un coágulo rodeando las células de S. aureus impidiendo que las células inmunológinas del hospedador entren en contacto con la bacteria e inicien la fagocitosis.
ß-lactamasa
Las ß lactamasas son enzimas que inactivan a la penicilina así evitando que esta misma llegue a las proteínas fijadoras de penicilina (proteínas fijadoras de peptidoglicano). Esta forma uno de los mecanismos de defensa de SARM (véase más adelante). Muchas de estas enzimas pueden inhibirse para así evitar que destruyan a las penicilinas susceptibles, esto se logra mediante la administración conjunta de una penicilina y un inhibidor de las ß-lactamasas (Ampicilina —Penicilina— y ácido clavulánico —Inhibidor—, por ejemplo).[23]
Lactato-deshidrogenasa
La resistencia al óxido nítrico es una cualidad peculiar de S. aureus, capacidad que lo distingue de otros patógenos, incluyendo los comensales S. epidermidis y S. saprophyticus. Esa resistencia se debe a que el microorganismo produce una enzima llamada lactato-deshidrogenasa, que la faculta para tolerar el estrés causado por el radical del óxido nítrico. Esta observación se ha hecho tanto en especies resistentes a la meticilina como en las que son susceptibles al antibiótico, así como en cepas hospitalarias como adquiridas en la comunidad.[6]
Otras enzimas estafilocócicas
Entre las otras enzimas estafilocócicas se encuentran:
- Hialuronidasa, una enzima que destruye el ácido hialurónico. Ayuda a la diseminación de los estafilococos.
- Fibrinolisina, también conoida como estfilocinasa, y disuelve los coagulos de fibrina.
- Lipasas, que ayudan a su supervivencia en regiones sebáceas.
- Nucleasas / DNasas, que ayuda al estafilococo a obtener nucleótidos.
Regulación de los factores de virulencia
La expresión de los factores de virulencia estafilocócicos está regulada por varios sistemas que detectan cambios en el ambiente. Estos sistemas constan de dos componentes, una cinasa sensora y un regulador de respuesta y funciona por medio de cascadas de fosforilación que culminan en la activación de transcripción. Se han estudiado varios sistemas reguladores en S. aureus que incluyen a los genes agr, saeRS, srrAB, arlSR y lytRS.[17]
El gen agr es el mejor estudiado y es esencial en el control de la percepción de quorum de la expresión genética, controla la expresión preferente de adhesinas de superficie (proteína A, coagulasa, proteína fijadora de fibronectina, entre otras)[3] así como la producción de toxinas, como TSST-1.[19]
Enfermedades clínicas
Staphylococcus aureus es el causante de diversos procesos infecciosos que van desde infecciones cutáneas hasta enfermedades sistémicas mortales.[1]
| Enfermedad | Descripción |
|---|---|
| Enfermedades mediadas por toxinas | |
|
Es un síndrome caracterizado por la descamación diseminada del epitelio de recién nacidos y lactantes; No se encuentran microorganismos o leucocitos en las ampollas. |
|
Sucede después de haber ingerido alimentos con la toxina termoestable. Se caracteriza por la presencia de vómitos intensos, diarrea y cólicos que inician entre 2 y 6 horas después de la ingesta. La resolución es rápida (menos de 24 h). |
|
Intoxicación multisistémica. Paciente con fiebre, hipotensión, vértigo ortostático, exantema maculo-eritematoso, vómito en muchas modalidades, diarrea, falla renal y una variedad de manifestaciones clínicas. Mortalidad elevada en ausencia de tratamiento. Por algún tiempo se asoció con tampones femeninos hiperabsorbibles. |
| Infecciones supurativas | |
| Es una acumulación de pus que puede darse en piel y mucosas. También puede darse en diferentes órganos (pulmón, hígado, riñón y cerebro) mediante la diseminación bacteriemica. Los abscesos deben desbridarse y la infección del material protésico requiere el retiro del mismo. | |
| Infección cutánea localizada caracterizada por la presencia de pústulas sobre base eritematosa. Se da preferentemente en niños y en zonas expuestas, en especial la cara. | |
| Es una infección restringida a los orificios de los folículos pilosos y se acompaña por la presencia de lesiones dolorosas, rojizas y pequeñas sin síntomas sistémicos. | |
| Son piodermas profundos que se presentan como lesiones elevadas, firmes, dolorosas y con centros necróticos que contienen material purulento. | |
| En este grupo se incluye la celulitis preseptal o preorbitaria, generalmente existe antecedente de lesión cutánea, se presenta con edema, dolor eritema local y fiebre. | |
|
Es la infección de las glándulas sudoríparas apócrinas bloqueadas. Se da en las áreas intertriginosas (axila, ingle, áreas perineales). Existe dolor, edema y eritrema, usualmente sin fiebre. |
| Es la infección de las glándulas mamarias asociada a parto y lactancia. Se encuentra edema, tumefacción, dureza y eritrema en las mamas. | |
| Se dan por soluciones de continuidad en la piel, pueden aparecer en el periodo postoperatorio si no se sigue una correcta técnica aséptica y existe enrojecimiento, tumefacción, dolor y presencia de drenaje sanguinolento turbio. | |
|
Es la diseminación de bacterias por el torrente sanguíneo, secundaria a una infección localizada en otra parte o por acceso directo a través de catéteres, terapia intravenosa o jeringas (drogadicción). Al distribuir organismos, se vuelve en la causa de infección de órganos internos. |
| Es la principal complicación de la bacteriemia. Daños hacia el revestimiento endotelial del corazón. También afecta a las válvulas cardíacas. Pueden auscultarse soplos. | |
| Infestación pulmonar, de predominio en pacientes de la tercera edad. Pueden originarse por apiración o como complicación de la bacteriemia. La neumonía por aspiración suele ser secundaria a infección por otro agente etiológico. | |
| Infección y destrucción ósea, en especial en la metáfisis de los huesos largos de los niños y la columna vértebral en adultos mayores. | |
| Articulación eritematosa dolorosa con material purulento en el espacio articular. | |
| Infección del sistema nervioso, se presenta en pacientes con antecedentes de traumatismos, cirugías, inmunodeficiencia, neoplasias malignas e hidrocefalia. | |
| Infección del peritoneo, el grupo de riesgo son los pacientes que reciben diálisis peritoneal ambulatoria. | |
| Infección del pericardio. Sucede como complicación de la endocarditis estafilocócica o por trauma penetrante en el tórax. | |
| La piomiositis es la infección de los músculos esqueléticos, en general, secundario a trauma o diseminación de infecciones subcutáneas. Aunque es un evento inicialmente descrito en forma más frecuente en áreas tropicales puede presentarse en cualquier zona climática e involucra la incapacidad funcional de la extremidad. | |
| Otras | |
|
Mediada por las coagulasas estafilocócicas. Es una complicación de la toxina de choque estafilocócico potencialmente mortal. |
Diagnóstico de laboratorio
| Diferencial | Métodología |
|---|---|
| Otros Staphylococcus |
|
Micrococcus
|
|
Macrococcus
|
|
Streptococcus
|
|
| Se describen las características que presentan los otros microorganismos y que son diferentes a S. aureus | |
Las pruebas de identificación de S. aureus pertenecen a 3 grupos: microscopía, cultivo y pruebas bioquímicas. Las bacterias diferenciales de S. aureus son: Staphylococcus catalasa negativos, Micrococcus, Macrococcus, Streptococcus, Enterococcus. La característica más confiable para la identificación de Staphylococcus aureus es la prueba de la coagulasa.
Obtención de las muestras
Las muestras para identificación pueden obtenerse del pus de la superficie, sangre, aspirado traqueal o líquido cefalorraquídeo, dependiendo de la ubicación del proceso infeccioso.[17]
Microscopía

En frotis teñidos con gram, los estafilococos aparecen como cocos grampositivos con diámetros de 0,5 hasta casi 1,5 μm. Se agrupan formando racimos cuando crecen en medio agar y aparecen solos, en pares, en cadenas cortas, en pequeños grupos o incluso dentro de polimorfonucleares cuando se aíslan de muestras clínicas.[1] Los cocos jóvenes son intensamente grampositivos; al envejecer, muchas células se vuelven gramnegativas. Si el paciente ha tomado antibióticos, muchos pueden aparecer lisados.[17] La sensibilidad de la observación microscópica de la muestra depende completamente de la toma de la misma, el tipo de la muestra y la infección (absceso, bacteriemia, impétigo, etc.). Los pares o cadenas de estafilococos en los frotis directos no pueden diferenciarse concretamente de Streptococcus, Micrococcus o Peptostreptococcus. No obstante, son claramente distintos al género Macrococcus ya que presenta un diámetro claramente mayor. El diagnóstico de estas enfermedades se basa en las manifestaciones clínicas del paciente y el aislamiento de S. aureus en el cultivo.[15]
Cultivo

Los estafilococos crecen rápidamente en casi todos los medios bacteriológicos bajo condiciones aerobias o microaerofílicas.[17] Las muestras clínicas principalmente se cultivan en medios de agar enriquecidos con sangre de carnero. Cuando se trata de una muestra contaminada, debe ser inoculada primero en agar Columbia adicionado con clistín y ácido nalidíxico o alcohol fenil-etílico[1]
| Tiempo de cultivo en Sal-manitol | |
|---|---|
| 24 h | Recomendado para los cultivos de muestras no contaminadas |
| 24-48 h | Usado en cultivos mixtos/contaminados. Recomendado para conseguir colonias de tamaño adecuado para microscopía y pruebas. |
| 72 h | Puede ser necesaria para aumentar la sensibilidad de las pruebas. |
Los Medios diferenciales para S.aureus son el medio manitol-salino o Chapman y el medio Baird-Parker. Entre los medios diferenciales comerciales se encuentran CHROMagar Staph aureus (Sensibilidad epidemiológica: 96,8%, 20 horas de incubación), tiñe las colonias de color malva y S. aureus ID agar (Sensibilidad epidemiológica: 91,1%, 20 horas de incubación), que tiñe las colonias de color verde. Estos medios comerciales verifican la presencia de α-glucosidasa dirante el desarrollo (las colonias de S.aureus coaglulasa negativos crecen en color azul, blanco o beige).[1] Su temperatura óptima de crecimiento va de 35 a 40 °C y el pH óptimo oscila entre 7,0 y 7,5 aunque soportan pH mucho más extremos. Soportan tasas elevadas de cloruro sódico, hasta un 15%.[17]
Morfología colonial

La morfología colonial es útil para distinguir entre especies de Staphylococcus y Micrococcus ya que la mayoría de las especies de Staphylococcus (incluido S. aureus) crecen más rápido y son más grandes en un cultivo a 24 h. Las colonias de S.aureus son grandes, lisas, enteras, presentan consistencia cremosa. Las colonias formadas por S.aureus suelen estar pigmentadas con colores que van del gris al amarillo o naranja, en condiciones anaerobias o en caldos no produce pigmento. Algunas cepas de S. aureus presentan β-hemólisis, que es más notable en cultivos con incubación prolongada.[17]
Usualmente, cuando el paciente es tratado con antibióticos, las muestras clínicas cultivadas suelen ser pequeñas y no pigmentadas, lo que disminuye la sensibilidad de la prueba al confundirse con micrococos.
Ácido-Glicerol-Eritromicina
Esta prueba utiliza un medio que contenga glicerol (1%), eritromicina (0,4 mcg/ml) y púrpura de bromocresol como indicador. Los cultivos se incuban durante 3 días y se clasifica como positiva si el medio se vuelve ácido. Los estafilococos producen ácido, los micrococos, no.
Pruebas de suceptibilidad
.jpg)
Estas pruebas determinan el crecimiento de una bacteria bajo la presencia de ciertos inhibidores. Puede realizarse de varias maneras, una de las más difundidas, la inclusión de discos en los cultivos. Estos discos liberan el antibiótico solo a una distancia corta por lo que se notará la falta de crecimiento bacteriano en la periferia del disco en caso de ser susceptible a tal antibiótico.
Staphylococcus aureus es sensible a furazolidona (disco 100 mcg) y resistente a bacitracina (0,04 unidades de bacitracina. Los estreptococos β-hemolíticos del grupo A son susceptibles).[17][15]
Pruebas bioquímicas
Entre las pruebas bioquímicas encontramos:
Coagulasa
La prueba de la coagulasa es sencilla y tiene una especificidad muy alta.[1] La prueba se puede realizar con un cultivo o en tubo y consiste en la búsqueda del factor de aglutinación. Se lleva a cabo con la administración de S. aureus a plasma de conejo con EDTA, al cabo de unas horas podrá verse la formación de un coágulo (prueba positiva). Puede usarse la aglutinación en látex y la Hemaglutinación pasiva como medio alternativo para detectar el factor de agregación.
Desoxirribonucleasa (DNasa)
Como se mencionó, S. aureus produce DNasa termoestable que es detectable en el medio de prueba del mismo nombre. Su uso es principalmente como confirmación diagnóstica.
Catalasa
Los estafilococos y los micrococos se diferencian de los estreptococos y los enterococos por esta prueba. Esta prueba detecta la presencia de enzimas-Catalasa o Peroxidasa. La prueba se realiza agregando una gota de peróxido de hidrógeno (3% vol) sobre la muestra en un portaobjetos de vidrio. Es positiva si se observa un burbujeo intenso. Entre la causa más frecuente de falsos positivos se encuentra el realizarla en un medio que contenga sangre (los eritrocitos pueden causar burbujeo) y la presencia de pseudocatalasa en algunas cepas estafilocócicas.
Sensibilidad a la lisostafina
Esta prueba mide la facilidad con la que los microorganismos estafilocócicos se lisan en presencia de lisostafina. Lisostafina es una endopeptidasa que rompe los puentes de entrecruzamiento de glicina en el peptidoglucano.
Entre las bacterias de lisis rápida y marcada encontramos: S. aureus, S. simulans, S.cohnii y S. xylosus; y las de lisis lenta o insensibles: S. hominis, S. saprophyticus y S. haemolyticus.
Oxidasa
Esta prueba es rápida, se usan discos de papel filtro con tetrametil-p-fenilendiamina como reactivo y DMSO para hacer permeables a las bacterias al reactivo. La prueba se basa en que evidenciar la reacción de óxido-reducción y se torna violeta a los 30 segundos cuando es positiva. Staphylococcus aureus, y la mayoría de las especies del mismo género son oxidasa-negativos.
Enzimoinmunoanálisis
Estas pruebas buscan la presencia de proteínas específicas de S. aureus, la mayoría de ellas busca a la proteína A y la β-N-acetilglucosaminidasa. La sensibilidad y especificidad de este estudio, en cultivos no contaminados es cercana al 100%.
Resistencia a antibióticos
Staphylococcus aureus ha desarrollado varios mecanismos para sobrevivir a los β-lactámicos y otros fármacos.[4] En los comienzos de la segunda década del siglo XXI, más del 80% de las cepas de S.aureus son resistentes a penicilina.[1]
Hiperproducción de β-lactamasas
La producción constitutiva de una gran cantidad de betalactamasas, por parte de algunas cepas de SA, le da la capacidad de hidrolizar lentamente a las penicilinas penicilinasa-resistentes.[27] Naturalmente Staphylococcus aureus produce una penicilasa estafilocócica, pero ciertos plásmidos ocasionan que exista una hiperproducción de esta enzima que degrada penicilinas naturales y en forma limitada, pero notable, penicilinas semisintéticas (principalmente Oxacilina y Meticilina). La concentración inhibitoria mínima (CIM) para oxacilina y meticilina en estos estafilococos es 1-2μg-ml y 2-4μg-ml, respectivamente.
En estas cepas de S. aureus se denominan borderline reistant Staphylococcus aureus(BORSA) y la mayoría de estas pertenece al fagogrupo 94/96 y poseen un pásmido de 17,2 Kb común que produce a la β-lactamasa estafilocócica del tipo A.[28]
Resistencia a meticilina, nafcilina y oxacilina

La resistencia a meticilina, nafcilina y oxacilina es independiente de la producción de β-lactamasas. Esta resistencia está codificada y regulada por una serie de genes que se encuentra en la región del cromosoma de S. aureus llamada Staphylococcal cassette chromosome mec (SCCmec, casete cromosómico estafilocócico).
El gen mecA, parte de SCCmec codifica una proteína fijadora de penicilina llamada PBP2a que presenta una baja afinidad por β-lactámicos que interviene en la resistencia. Con una afinidad tan baja esta proteína no sirve como blanco para las penicilinas ya que tiene una baja afinidad por los β-lactamicos. El Staphylococcus aureus portador del gen mecA expresa tanto PBP(sensible) como PBP2(resistente). Cuando recibe un ataque con β-lactámicos, se inactivan las PBP sensibles, pero siguen funcionando las PBP resistentes permitiendo la síntesis de peptidoglucano estable.[17]
Existen varios tipos de SCCmec, los SCCmec de tipo I, II y III se asocian con infecciones intrahospitalarias y podrían contener genes que codifiquen la resistencia para otros antimicrobianos. SCCmec de tipo IV se relaciona con cepas de SARM extrahospitalarias (véase más adelante).[4]
Resistencia a vancomicina
En Estados Unidos, se considera que S. aureus es resistente a vancomicina si CIM ≥ 16 mcg/ml, moderadamente resistente si CIM está entre 2 y 8 mcg/ml y susceptible si CIM ≤ 2 mcg/ml.[17]
S. aureus resistente-intermedio a vancomicina (VISA, Vancomicin-intermediate Staphylococcus aureus) ha sido aislado en Japón, Estados Unidos y muchos otros países. La resistencia intermedia a vancomicina se desarrolla en pacientes que han recibido tratamiento prolongado con vancomicina. Este tipo de resistencia se relaciona con un incremento en la síntesis de la pared celular y no a los genes van enterocócicos.[23]
S. aureus resistente a vancomicina (VRSA, vancomycin-resistant S. aureus) desarrolla resistencia a vancomicina al adquirir el gen resistencia van de los enterococos y/o el gen mecA de resistencia a meticilina.[23]
Resistencia a otros fármacos
La resistencia a antimicrobianos como tetraciclinas, eritromicina, aminoglucósidos, entre otros, usualmente está mediada por plásmidos.
Staphylococcus aureus resistente a meticilina
| Infecciones por Staphylococcus aureus resistente a meticilina | ||
|---|---|---|
![]() Absceso causado por S. aureus resistente a meticilina. | ||
| eMedicine | overview/228816 | |
| Sinónimos | ||
| SARM, MRSA, Staphylococcus aureus meticilinorresistente | ||
Las cepas de S. aureus que expresan el gen mecA se denominan Staphylococcus aureus resistente a meticilina (SARM/MRSA).[27] La trascendencia clínica de este microorganismo radica en que dificulta el tratamiento de las infecciones que produce y obliga a establecer una serie de medidas de control en el ámbito nosocomial.[29]
SARM es un S. aureus resistente a todos los betalactámicos (excepto las cefalosporinas de 5.ª generación) y usualmente a aminoglucósidos, eritromicina, clindamicina, tetraciclinas, sulfamidas, quinolonas y rifampicina. Aun así, muestra cierta sensibilidad a los glucopéptidos.
Detección de laboratorio
Los métodos utilizados para la detección de SARM en el laboratorio se basan en la modificación de las condiciones de cultivo para facilitar la expresión de las cepas con resistencia a meticilina. La temperatura de incubación se reduce a 35 °C, se aporta NaCl al medio de cultivo y se prolonga el tiempo de incubación a 24 h.[30] En la actualidad también se dispone de métodos de diagnóstico rápido fenotípicos, como la aglutinación con anticuerpos monoclonales específicos, o genómicos, como la reacción en cadena de la polimerasa (PCR), que detecta el gen mecA.[29]
Epidemiología
SARM se presenta habitualmente en el ámbito hospitalario causando brotes nosocomiales o, con menos frecuencia, de forma esporádica. La introducción del SARM en el hospital se produce generalmente a través del denominado caso índice. Una vez en el centro, SARM puede transmitirse de forma limitada, dando lugar a una situación de endemia, o diseminarse rápidamente por todo el hospital, ocasionando un brote epidémico.[29]
Las medidas de control del SARM se basan en la epidemiología de esta infección y tienen por objeto limitar la diseminación nosocomial del microorganismo.[29]
Resistencia a antibióticos
Con excepción de la penicilina, ampicilina y vancomicina; todos los demás antimicrobianos presentan diferencia estadísticamente significativa entre cada categoría de S. aureus con respecto a sus susceptibilidad a la meticilina, siendo más sensibles los Staphylococcus aureus meticilino-sensibles que los BORSA (borderline Staphylococcus aureus), y estos más que los SARM.[31]
Tratamiento
| Sensibilidad o resistencia | Fármaco de elección | Alternativa | Comentarios |
|---|---|---|---|
| Sensible a penicilina | Penicilina G 4 mill. unidades cada 4 horas |
|
Menos del 5% de las cepas son sensibles a penicilina. |
| Sensible a meticilina |
|
|
Los pacientes alérgicos a penicilina pueden ser tratados con cefalosporinas si la alergia no involucra una reacción anafiláctica. |
| Resistente a meticilina | Vancomicina D* 30 mg/kg + 1 g cada 12 horas (dosificación estándar) o 15 - 20 mg/kg cada 8 h (se sugiere ajuste por TDM). |
|
Se recomienda el uso de un antibiograma para guiar la terapéutica. |
| Resistente a meticilina e intermedio a vancomicina | Inseguro | ||
| Resistencia/susceptibilidad desconocida | Vancomicina 1 g cada 12 horas |
(ninguno) | El antibiograma está indicado. Puede usarse vancomicina con un aminoglucósido. |
| Salvo donde se indique, la vía de administración es intravenosa. | |||
En un inicio, el tratamiento de elección contra infecciones graves por este microorganismo era penicilina. Pero debido a que el 80% de S. aureus es resistente a penicilina, las penicilinas resistentes a penicilasas (oxacilina, nafcilina, dicloxacilina y meticilina) son los fármacos de elección.[1]
Debido a que los estafilococos son ubicuos y a que forman parte de la microbiota normal, ocurrirá una reinfección en superficies expuestas como la piel. Los microorganismos suelen diseminarse del lugar de infección, si este se encuentra en la piel o superficies expuestas es importante mantener antisepsia local. En afecciones cutáneas severas, como furunculosis, se utilizan tetraciclinas para el tratamiento a largo plazo.[17]
Un nuevo abordaje terapéutico es la utilización de anticuerpos monoclonales contra las proteínas MSCRAMM, este había obtenido resultados prometedores en el comienzo de la segunda década del siglo XXI.[15]
El monitoreo terapéutico (TDM por sus siglas en inglés: Therapeutic Drug Monitoring) de los glicopéptidos (por ej. vancomicina y teicoplanina) puede ser una herramienta importante para individualizar y así optimizar los tratamientos farmacológicos. Sobre la base de la aplicación adecuada del TDM, y criterios farmacocinético clínicos, sería posible disminuir la probabilidad de aparición de eventos adversos y aumentar la probabilidad de obtener los efectos clínicos deseados.[32]
Alternativas
Ante la constante adaptación de Staphylococcus aureus a los antibióticos se han desarrollado tratamientos alternativos contra diferentes cepas:
- Staphylococcus aureus resistente a meticilina (SARM). Para infecciones ambulatorias se recomienda clindamicina, trimetoprim-sulfametoxazol o doxiciclina.[15]
- Staphylococcus aureus con resistencia intermedia a vancomicina (VISA). Son susceptibles a oxazolinidonas y Quinutripsina/Dalfopristina.[17]
- Staphylococcus aureus con resistencia a vancomicina (VRSA). Solicitar antibiograma.
Profilaxis
Prevenir la transmisión horizontal de estafilococos de una persona a otra es sumamente difícil, no obstante, seguir medidas como una buena técnica aséptica, difundir el correcto lavado de manos (no solo a nivel hospitalario) y la cobertura de las superficies de piel expuestas son buenas medidas para prevenir infecciones por este (y otros) microorganismos.[15] En marzo de 2012 se estaba preparando una vacuna anti-estafilocócica usando un complejo proteínico con polisacárido capsular y había tenido un buen desempeño en modelos animales de enfermedad, no obstante, seguía en etapa de evaluación preclínica.[3]
Posibles efectos immunoterapeuticos en cáncer
Un estudio retrospectivo en pacientes con cáncer de pulmón encontró que aquellos que sufrían enfisema luego de una intervención quirúrgica tenían una supervivencia sustancialmente mayor que los que no (50% vs. 18%). Staphylococcus aureus fue uno de los organismos aislados en la cavidad pleural, junto con Escherichia coli, Pseudomonas aeruginosa y Candida albicans.[33]
Véase también
- Staphylococcus
- Bacteria
- Forúnculo
- Microbiota normal
- Staphylococcus aureus resistente a meticilina
- Enterotoxina
- Infección oportunista
- Colangitis aguda
- Tinción de Gram
Notas
Referencias
- ↑ a b c d e f g h i j k l m n ñ o p Winn et al., Propcop
- ↑ a b c d e f g h i j Hurtado, MP; de la Parte, MA; Brito A (Julio de 2002). «Staphylococcus aureus: Revisión de los mecanismos de patogenicidad y la fisiopatología de la infección estafilocócica.» (HTML). Rev Soc Ven Microbiol (Venezuela: Scielo) 22 (2): 112-118. ISSN 1315-2556. Archivado desde el original el 14 de junio de 2013. Consultado el 22 de enero de 2012.
- ↑ a b c d e f g h i j k l Lowy, Franklin D. (20 -agosto-1998). «Staphylococcus aureus infections» [Infección por Staphylococcus aureus] (PDF). NEJM (en inglés) (Estados Unidos: Massachusetts Medical Society) 339 (8): 520-532. ISSN 0028-4793. doi:10.1056/NEJM199808203390806. Versión impresa:ISSN 533-4406. Consultado el 7 de febrero de 2012. (requiere suscripción).
- ↑ a b c d e Gil de M, Mónica (2000). «Staphylococcus aureus: Microbiología y aspectos moleculares de la resistencia a meticilina» (PDF). Revista chilena de infectología (Chile: Scielo) 17 (2): 145-152. ISSN 0716-1018. Consultado el 29 de enero de 2012. (requiere suscripción).
- ↑ Barret FF; McGhee RP; Finland M (29 de agosto de 1968). «Methicillin-resistant Staphylococcus aureus at Boston City Hospital - Bacteriologic and Epidemiologic Observations» [Staphylococcus aureus resistente a meticilina en un hospital de la ciudad de Boston - Observaciones bacteriológicas y epidemiológicas] (PDF). NEJM (en inglés) (Estados Unidos: Massachusetts Medical Society) 279 (9): 441-8. ISSN 1533-4406. PMID 4232865. doi:10.1056/NEJM196808292790901. Consultado el 29 de enero de 2012. (requiere suscripción).
- ↑ a b Richardson, AR; Libby SJ, Fang FC (21 de marzo de 2008). «A nitric oxide-inducible lactate dehydrogenase enables Staphylococcus aureus to resist innate immunity» (PDF). Science (en inglés) (Estados Unidos: American Association for the Advancement of Science) 319 (5870): 1672-6. ISSN 1095-9203. PMID 18356528. doi:10.1126/science.1155207. Consultado el 29 de enero de 2011. (requiere suscripción).
- ↑ Tuazon CU; Pérez A; Kishaba T; Sheagren JN. «Staphylococcus aureus among insulin-injecting diabetic patients: an increased carrier rate» [Staphylococcus aureus en pacientes diabéticos insulinodependientes]. JAMA 1975 (231): 1272.
- ↑ Tuazon CU; Sheagren JN. «Increased rate of carriage of Staphylococcus aureus among narcotic addicts» [La elevada tasa de portador de Staphylococcus aureus en pacientes adictos a narcóticos]. J Infect Dis 1974 (129): 725-7.
- ↑ Yu VL; Goetz A; Wagener M; et al. «Staphylococcus aureus nasal carriage and infection in patients on hemodialysis: efficacy of antibiotic prophylaxis» [Transporte nasal e infección por Staphylococcus aureus en pacientes en hemodialisis: eficacia de la profilaxis antibiótica]. N Engl J Med 1986 (315): 91-6.
- ↑ Weinstein HJ. «The relation between the nasal staphylococcal carrier state and the incidence of postoperative complications» [La relación entre el estado de portador nasal estafilocócico y la incidencia de complicaciones post-operatorias]. N Engl J Med 1959 (260): 1303-8.
- ↑ Weinke T; Schiller R; Fehrenbach FJ; Pohle HD. «Association between Staphylococcus aureus nasopharyngeal colonization and septicemia in patients infected with the human immunodeficiency virus» [Asociación entre la colonización nasofaríngea y septicemia por Staphylococcus aureus en pacientes infectados con el virus de inmunodeficiencia humana]. Eur J Clin Microbiol Infect Dis 1992 (11): 985-9.
- ↑ Sanford MD; Widmer AF; Bale MJ; Jones RN; Wenzel RP. «Efficient detection and long-term persistence of the carriage of methicillin resistant Staphylococcus aureus.» [Detección eficiente y persistencia de portador de Staphylococcus aureus resistente a meticilina]. Clin Infect Dis (en inglés) 1994 (19): 1123-8.
- ↑ a b
- ↑ Emori TG; Gaynes RP. «An overview of nosocomial infectiones, including the role of the microbiology laboratory» [Revisión de las infecciones nosocomiales, incluyendo el papel del laboratorio de microbiología]. Clin microbiol review (en inglés) 1993 (6): 428-442. PMC 358296. PMID 8269394. Archivado desde el original el 27 de septiembre de 2018. Consultado el 7 de febrero de 2010. (requiere suscripción).
- ↑ a b c d e f g h i j k l m n ñ o p q r Murray, Patrick R.; Rosenthal, Ken S.; Pfaller, Michael A. (Abril de 2009). «Staphylococcus y cocos grampositivos relacionados». En Patrick R. Murray, ed. Microbiología Médica. 6 Ed (6.ª edición). España: Elsevier-Mosby. pp. 209-224. ISBN 978-84-8086-465-7. OCLC 733761359.
- ↑ Kessler CM; Nussbaum E; Tuazon CU. «Diseminated intravascular coagulation associated with Staphylococcus aureus septicemia is mediated by peptidoglycan-induced platelet agregation» [La coagulación intravascular diseminada asociada con septicemia por Staphylococcus aureus es mediada por la agregación plaquetaria inducida por peptidoglucano] (PDF). J Infect Dis (en inglés) 1991 (164): 101-7. PMID 2056198. doi:10.1093/infdis/164.1.101. Consultado el 7 de febrero de 2010.
- ↑ a b c d e f g h i j k l m Brooks, Geo. F.; Carroll, Karen C.; Butel, Janet S.; Morse, Stephen A.; Mietzner, Timothy A. (2011). «Capítulo 13: Staphylococcus». En Jawetz, ed. Jawetz, Melnick y Adelberg Microbiología médica. José Rafael Blengio Pinto (traductor) (25.ª edición). Estados Unidos: McGraw-Hill-Lange. pp. 185-194. ISBN 978-607-15-0503-3. OCLC 757476276. Edición inglesa: ISBN 978-0-07-162496-1.
- ↑ U.S. National Library of Medicine (ed.). «Taxonomy browser. Staphylococcus aureus». National Center for Biotechnology Information (en inglés). Consultado el 7 de marzo de 2012.
- ↑ a b Cheung AL; Eberhardt KJ; Chung E; et. al. (1994). «Diminished virulence of a sar-agr mutant of Staphylococcus aureus in the rabbit model of endocarditis.» [Disminución de la virulencia de Staphylococcus aureus sat-agr mutado en el modelo de endocarditis en conejo.]. J Clin Investagr (en inglés) 1994 (94): 1815-22.
- ↑ Di Bella, Stefano; Marini, Bruna; Stroffolini, Giacomo; Geremia, Nicholas; Giacobbe, Daniele Roberto; Campanile, Floriana; Bartoletti, Michele; Alloisio, Giulia et al. (5 de mayo de 2025). «The virulence toolkit of Staphylococcus aureus: a comprehensive review of toxin diversity, molecular mechanisms, and clinical implications». European Journal of Clinical Microbiology & Infectious Diseases (en inglés). ISSN 0934-9723. doi:10.1007/s10096-025-05148-y. Consultado el 13 de julio de 2025.
- ↑ a b c d Gerard Lina; Yves Piémont; Florence Godail-Gamot; Michèle Bes; Marie-Odile Peter; Valérie Gauduchon; François Vandenesch; Jerome Etienne (9 de junio de 1999). Involvement of Panton-Valentine Leukocidin—Producing Staphylococcus aureus in Primary Skin Infections and Pneumonia [Participación de la leucocidina de Panton-Valentine producida por Staphylococcus aureus en las infecciones cutáneas] (PDF). ISSN 1537-6591. PMID 10524952. doi:10.1086/313461. Edición impresa:ISSN 1058-4838. «Publicación gratuita por el editor».
- ↑ Armando Bécquer Lombard; Virginia Leyva Castillo; César Lara Ortiz; Lidia Mota de la Garza (julio de 1997). «Staphylococcus aureus, actividad termonucleasa y enterotoxinas en alimentos» (HTML). Rev Cubana Aliment Nutr (Cuba: Biblioteca Virtual en Salud) 11 (2): 89-93. ISSN 1561-2929. Versión impresa ISSN 0864-2133. Archivado desde el original el 8 de febrero de 2012. Consultado el 22 de enero de 2012. «Instituto de Nutrición e Higiene de los Alimentos».
- ↑ a b c Chambers, Henry F.; Deck Daniel H. (2009) [Primera edición: 1982]. «Capítulo 43: Lactámicos β y otros antibióticos activos en la pared y al membrana celulares». Escrito en Estados Unidos. En Bertram G Katzung; Susan B Masters; Anthony J Trevor, eds. Farmacología básica y clínica. Lange médical book (11.ª edición). México: McGraw-Hill-Lange. pp. 773-793. ISBN 978-607-15-0336-7. OCLC 699461359.
- ↑ a b c d e f g Kumate, Jesús; Gutiérrez, Gonzalo; Muñoz, Onofre; Santos, Ignacio; Solórzano Fontino; Miranda Guadalupe (2008). «Capítulo 41: Infecciones en la piel y tejidos blandos». Infectología Clínica Kumate-Gutiérrez (17.ª edición). México: Méndez Editores (publicado el 2009). pp. 455-467. ISBN 968-5328-77-3. OCLC 728653050.
- ↑ a b Carrillo Soto, Irma Araceli; Barajas Colón, José Ángel; González Alanis, Alfredo Federico (29-ago-2011). «Capítulo 6: Clasificación de la patología quirúrgica menor susceptible de tratamiento en el primer nivel de atención». En Dr. Jesús Tápia Jurado; Dr.Abel Archundia García; Dr. Wulfrano Antonio Reyes Arellano, eds. Introducción a la cirugía. México: McGraw-Hill (publicado el 20-sep-2011). pp. 73-107. ISBN 978-607-02-2469-0.
- ↑ Tu, Kevin K. y Palutke, Waldemar A (1976). «Isolation and Characterization of a Catalase-Negative Strain of Staphylococcus aureus». Journal of Clinical Microbiology 3 (1): 77-78.
- ↑ a b Galiana Villar, Álvaro (2003). «Infección por Staphylococcus aureus meticilino resistente adquirido en la comunidad». Arch. Pediatr. Urug. 74 (1): 26-29. Archivado desde el original el 18 de mayo de 2013. Consultado el 29 de enero de 2012.
- ↑ Musser J, Kapur V. (1992). «Clonal analysis of methicillin-resistant Staphylococcus aureus strains from intercontinental sources: Association of the mec gene with divergent phylogenetic lineages implies dissemination by horizontal transfer and recombination». J Clin Microbiol (en inglés) (30): 2058-63.
- ↑ a b c d Sopena Nieves; Sabrià Miquel (2002). «Staphylococcus aureus resistente a la meticilina» (PDF). Escrito en España. Med Cin (Barc) (Estados Unidos: Elsevier) 118 (17): 671-6. ISSN 0025-7753. Consultado el 30 de enero de 2012. (requiere suscripción). Resumen divulgativo – Elsevier (2002).
- ↑ National Committee for Clinical Laboratory Standards. «Performance standards for antimicrobial susceptibility testing». NCCLS approved standard M100-S9. National Committee for Clinical Laboratory Standards, Wayne, PA. 1999.
- ↑ Mendoza Ticona, Carlos Alberto; Velázquez Talavera, Renato; Mercado Díaz, Ludwig, et ál. (oct. 2003). «Susceptibilidad antimicrobiana de Staphylococcus aureus sensible, con sensibilidad "BORDERLINE" y resistentes a la meticilina». Rev Med Hered 14 (4): 181-185. ISSN 1018-130X.
- ↑ Caceres Guido, Paulo; Alicia Moroni, Guillermo Bramuglia, Gabriel Mato (junio de 2008). «MONITOREO TERAPEUTICO DE DROGAS». Medicina Infantil 15 (2): 156-8.
- ↑ Ruckdeschel, J. C., Codish, S. D., Stranahan, A., & McKneally, M. F. (1976). «Postoperative Empyema Improves Survival in Lung Cancer». New England Journal of Medicine. doi:10.1056/NEJM197211162872004.
Bibliografía
- Brooks, Geo. F.; Carroll, Karen C.; Butel, Janet S.; Morse, Stephen A.; Mietzner, Timothy A. (2011). «Capítulo 13: Staphylococcus». En Jawetz, ed. Jawetz, Melnick y Adelberg Microbiología médica. José Rafael Blengio Pinto (traductor) (25.ª edición). Estados Unidos: McGraw-Hill-Lange. pp. 185-194. ISBN 978-607-15-0503-3. OCLC 757476276. Edición inglesa: ISBN 978-0-07-162496-1.
- El enlace es una vista de un resumen divulgativo.
- Kumate, Jesús; Gutiérrez, Gonzalo; Muñoz, Onofre; Santos, Ignacio; Solórzano Fontino; Miranda Guadalupe (2008). «Capítulo 41: Infecciones en la piel y tejidos blandos». Infectología Clínica Kumate-Gutiérrez (17.ª edición). México: Méndez Editores (publicado el 2009). pp. 455-467. ISBN 968-5328-77-3. OCLC 728653050.
- Murray, Patrick R.; Rosenthal, Ken S.; Pfaller, Michael A. (Abril de 2009). «Capítulo 21:Staphylococcus y cocos grampositivos relacionados». En Patrick R. Murray, ed. Microbiología Médica. 6 Ed (6a edición). España: Elsevier-Mosby. pp. 209-224. ISBN 978-84-8086-465-7. OCLC 733761359.
- Winn; Allen; Janda; Koneman; Propcop; Schreckenberger; Brooks (enero de 2008). «Capítulo 12: Cocos grampositivos: Parte1: Estafilococos y cocos grampositivos relacionados» (Google Books). Escrito en Argentina. Koneman:Diagnóstico microbiiológico. Texto y atlas en color (6a edición). Estados Unidos: Editorial médica panamericana. pp. 593-638. ISBN 978-950-06-0895-4. Consultado el 29 de enero de 2012. La versión online es una vista previa limitada a ciertas páginas.
Enlaces externos
Wikimedia Commons alberga una galería multimedia sobre Staphylococcus aureus.
Wikispecies tiene un artículo sobre Staphylococcus aureus.- En MedlinePlus hay más información sobre Staphylococcus aureus
- Recursos de microbiología en Facultad de Medicina (UNAM).
- Staphylococcus aureus resistente a meticilina en Centros para el Control y Prevención de Enfermedades (Estados Unidos)
- SARM en Universidad de Los Andes (Venezuela)
- Staphylococcus aureus en el Bad Bug Book de la FDA (en inglés).
- Staphylococcus aureus en Libro de texto de bacteriología en línea de Todar (en inglés).
- Infecciones causadas por cocos en Manual Merck
- Staphylococcus aureus en Kid's health
- Staphylococcus aureus (Aspectos moleculares) en Scielo
- Staphylococcus aureus en: medicinenet.com (en inglés)


